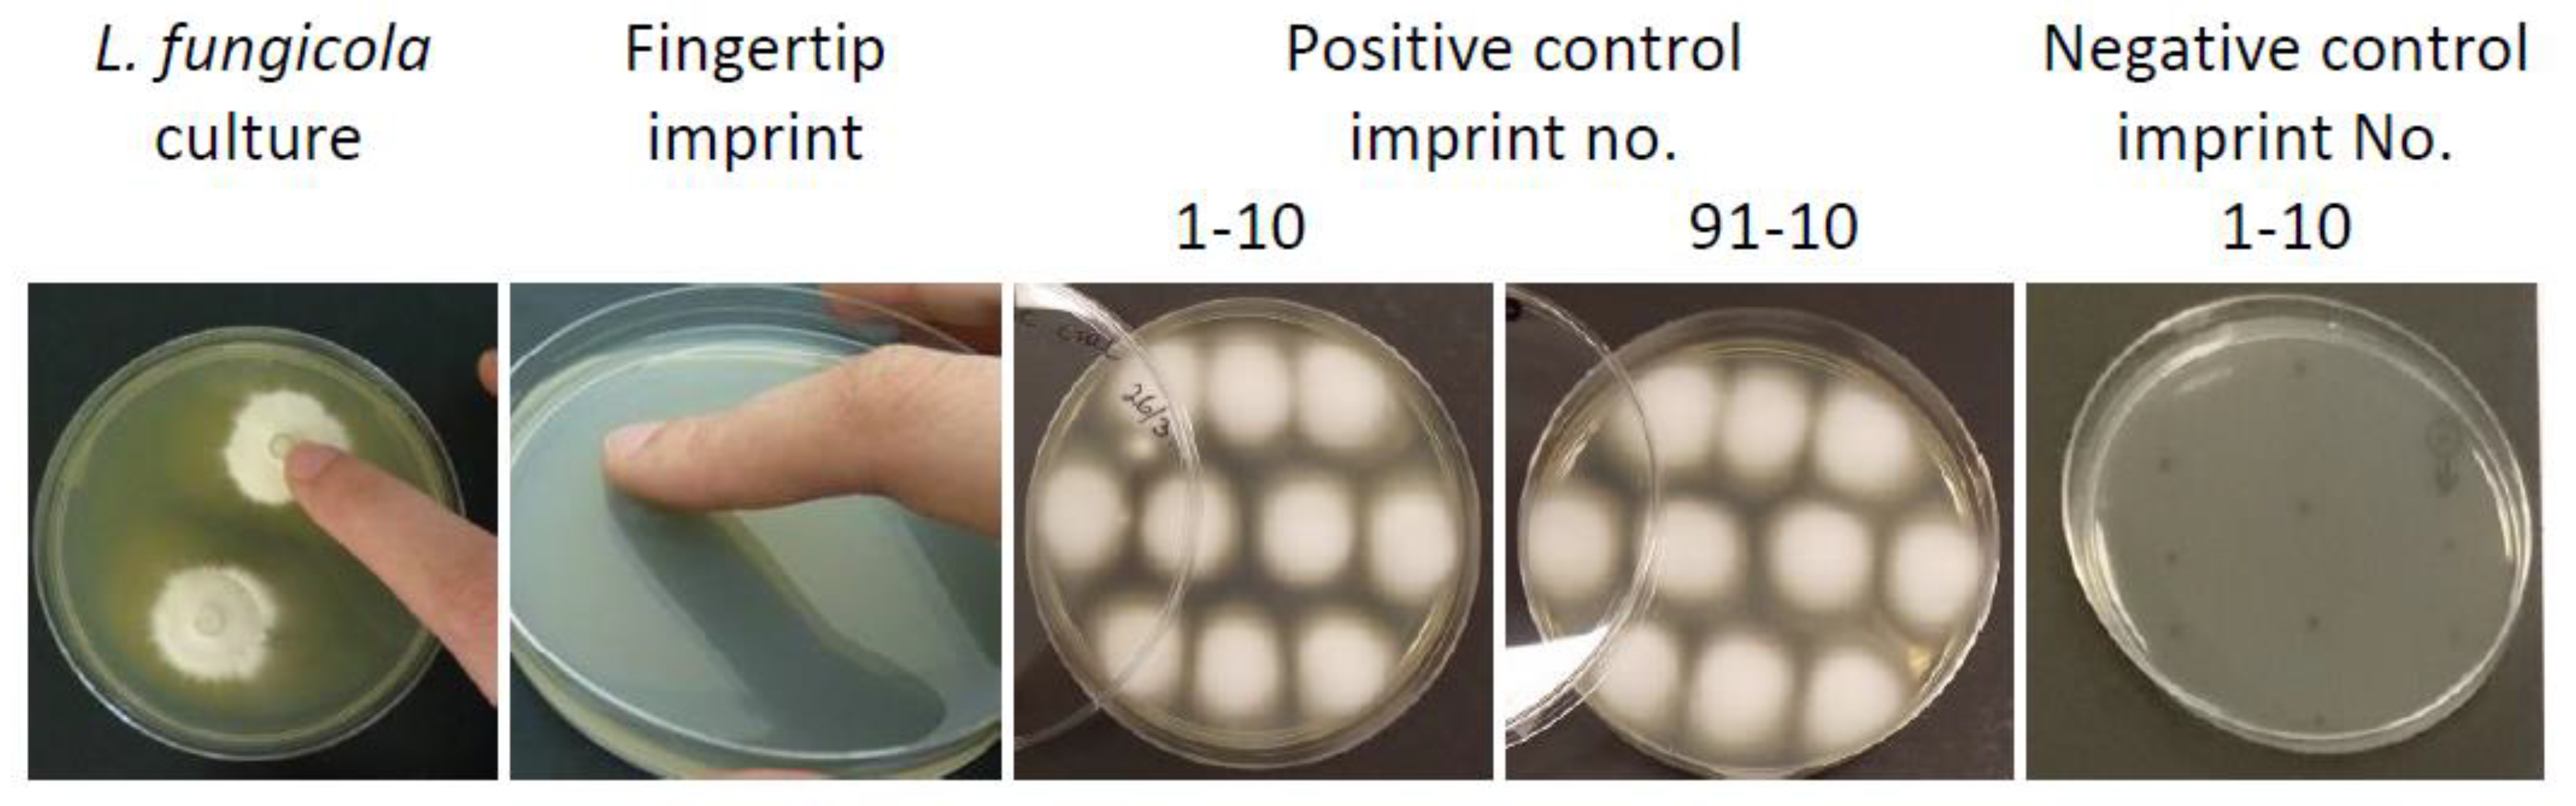
Agronomy 11 01600 g002
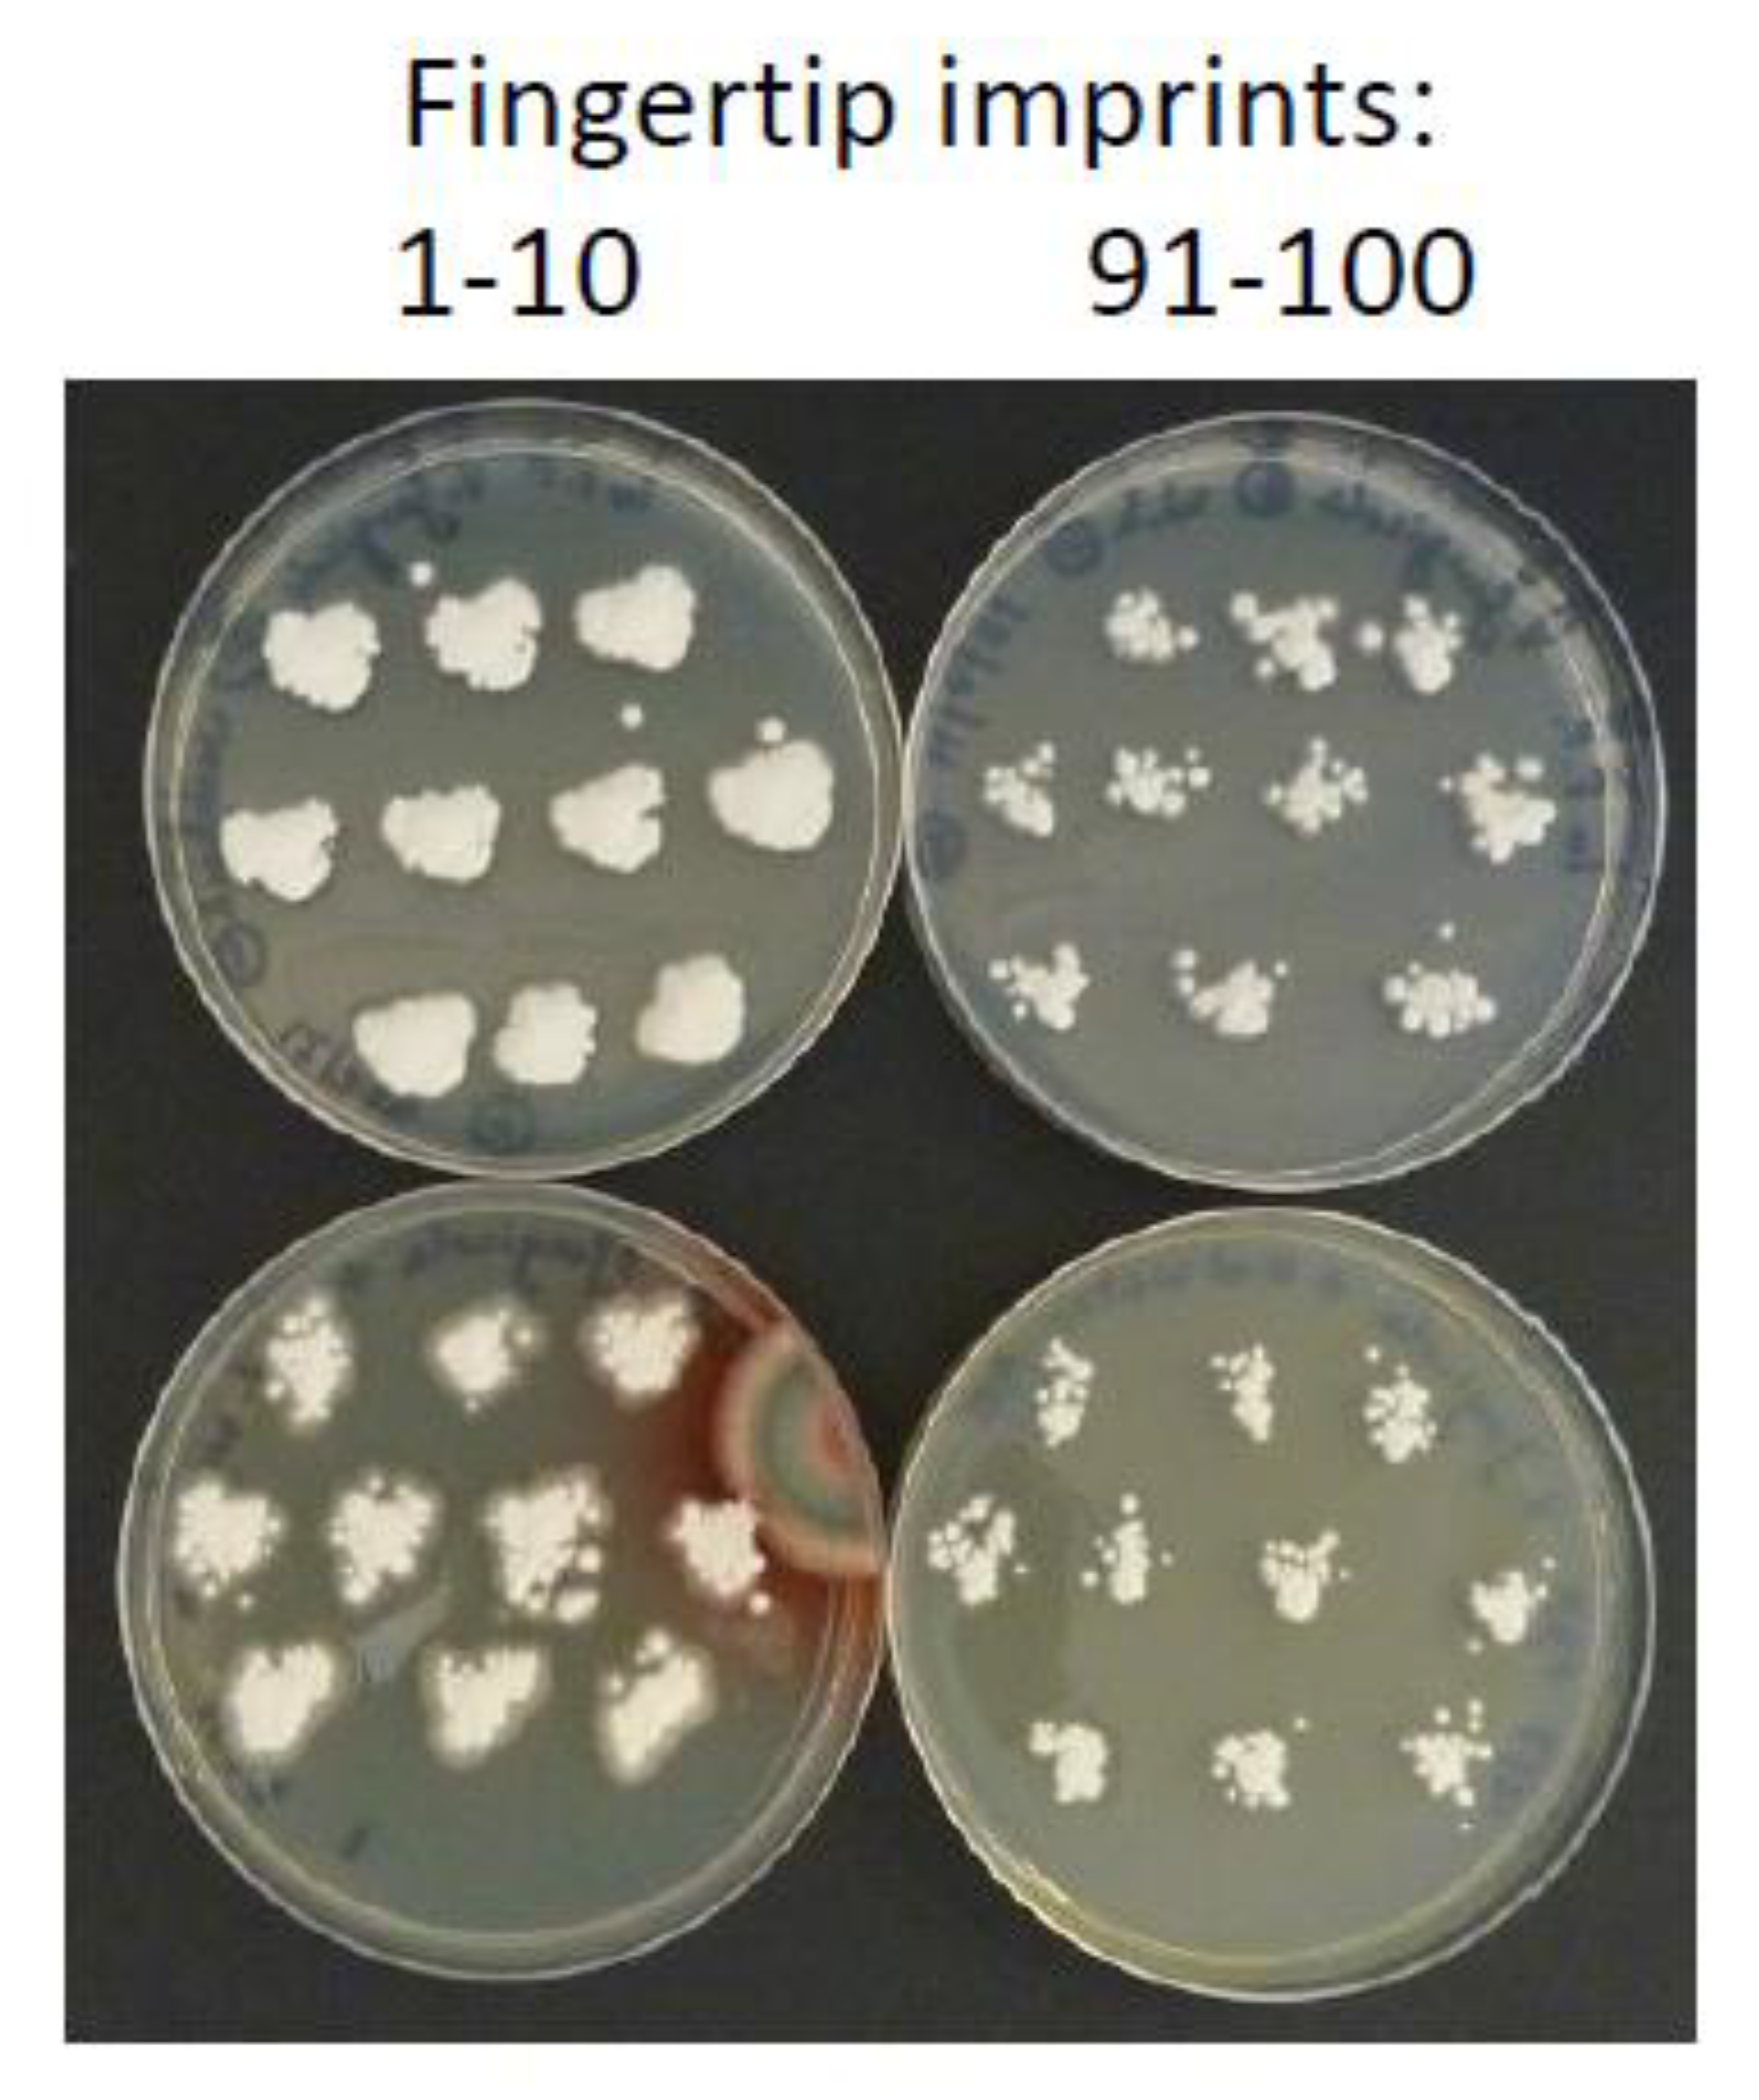
Agronomy 11 01600 g003
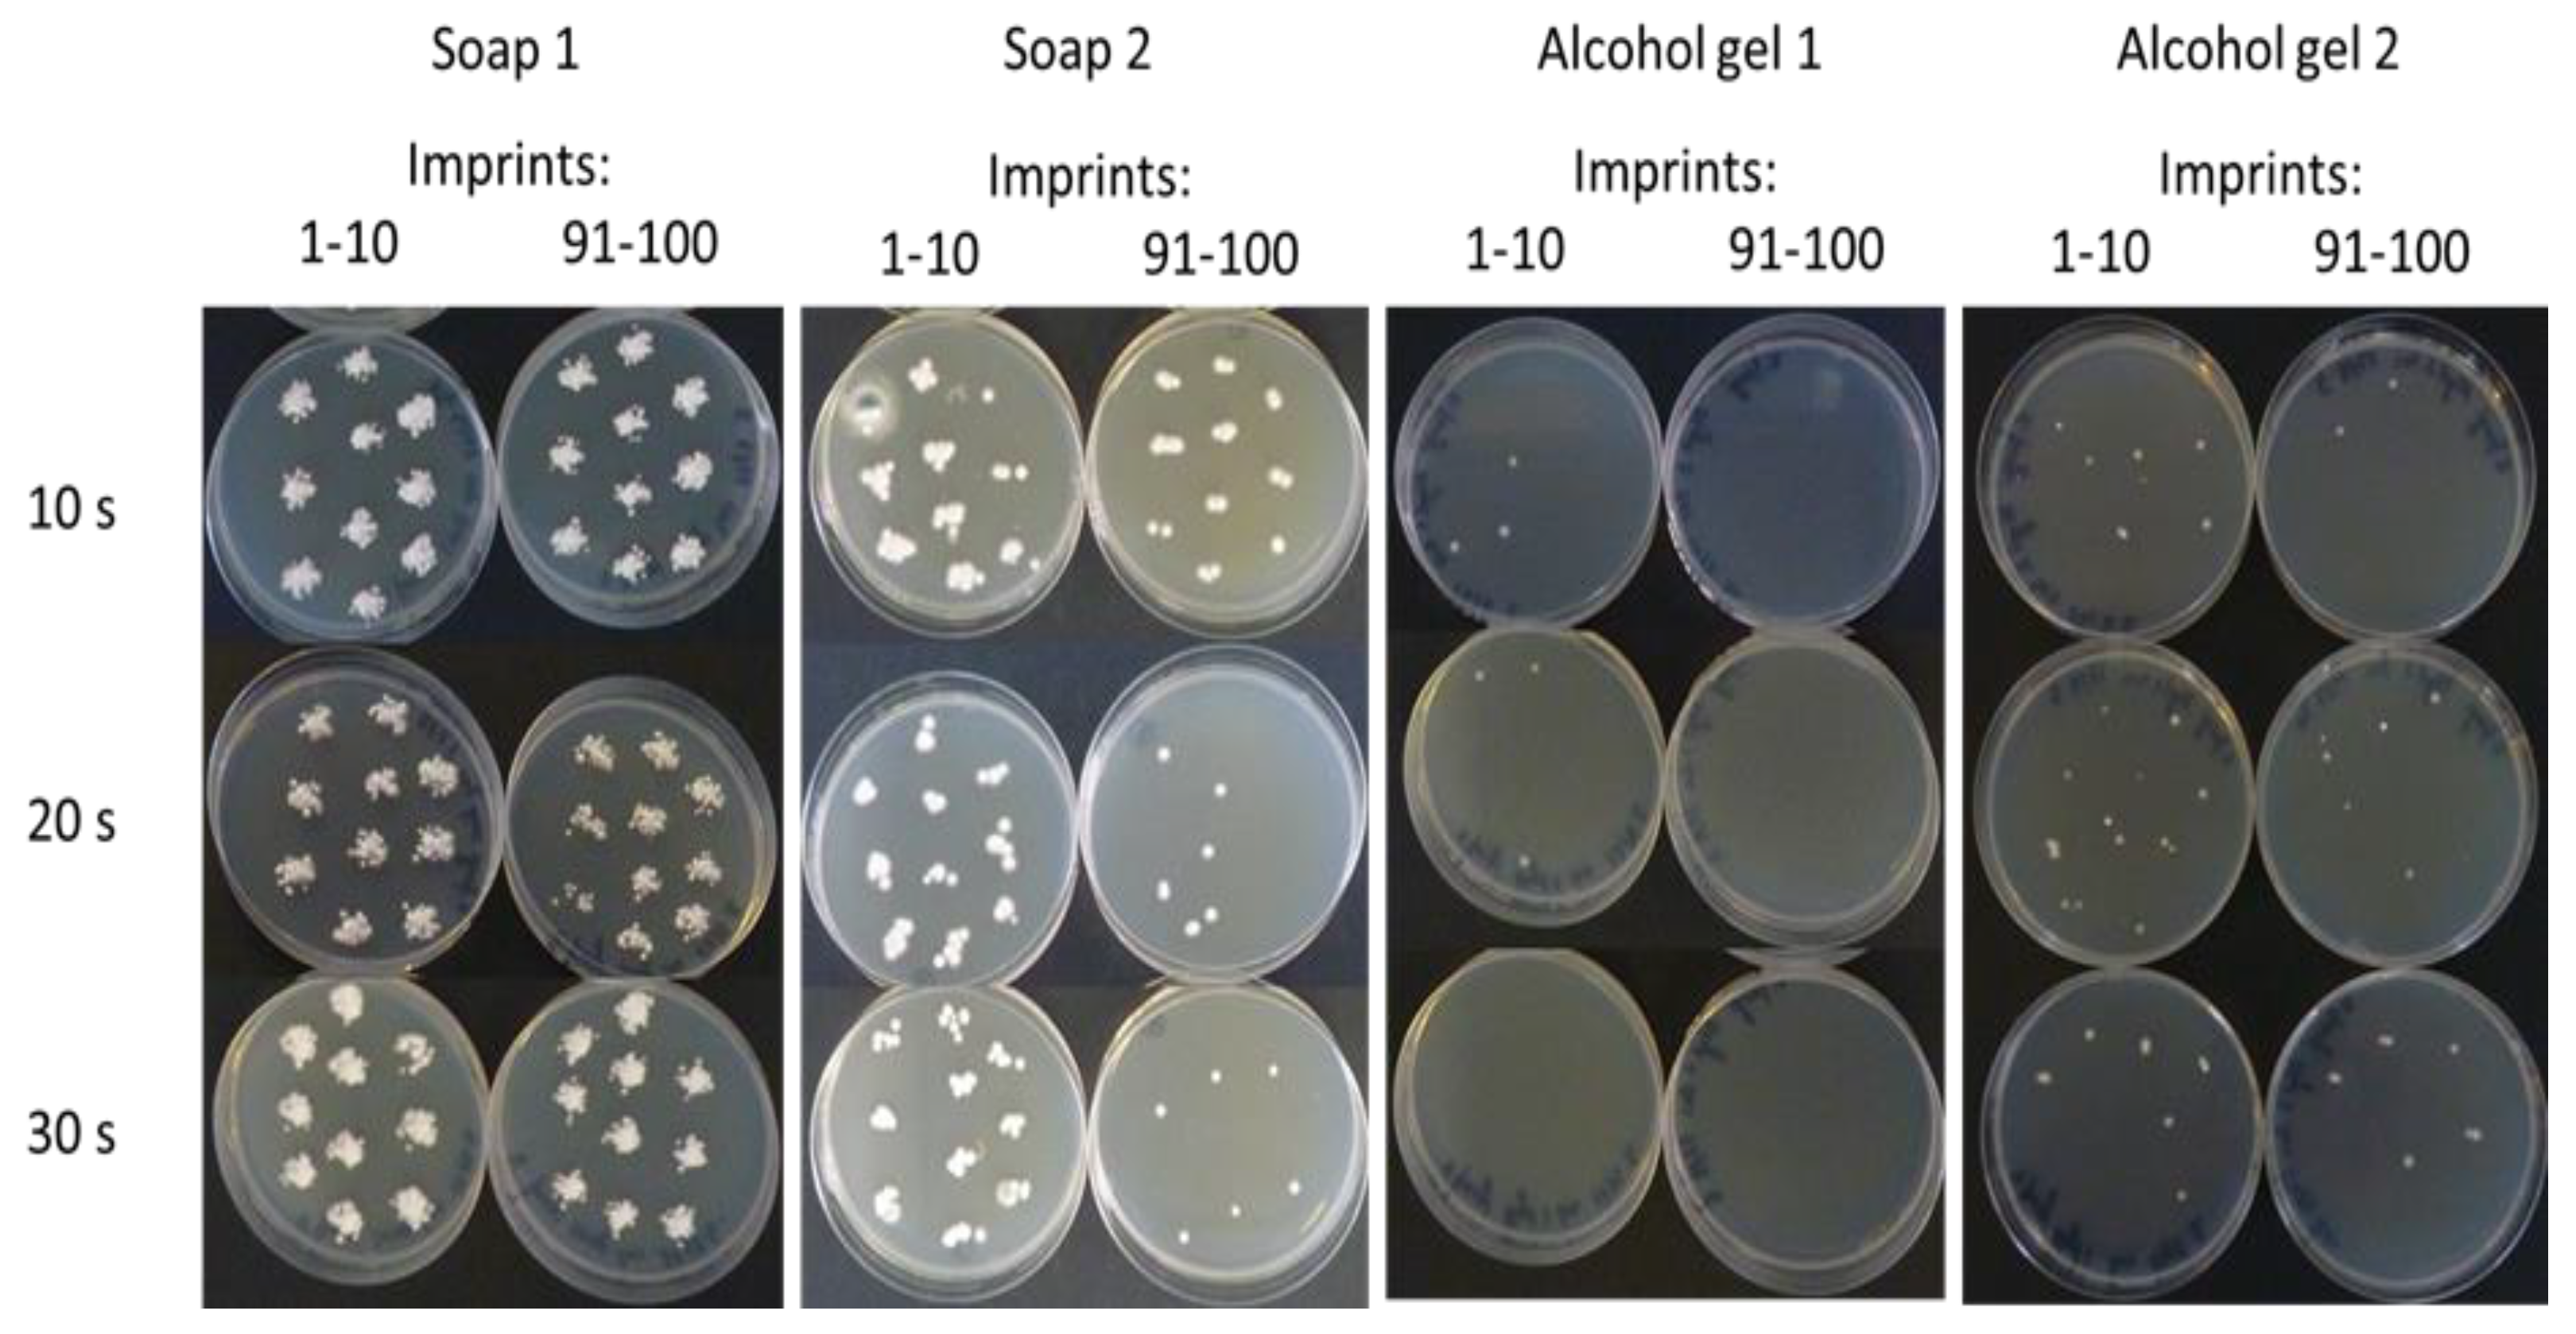
Agronomy 11 01600 g004

Efficacy of Liquid Soap and Alcohol-Based Hand Sanitisers in Eradicating Viable Conidia of the Mushroom Pathogen Lecanicillium fungicola on Contaminated Hands
Abstract
:1. Introduction
2. Materials and Methods
2.1. Fungal Culture
2.2. Hand Cleaning Products
2.3. Preliminary In Vivo Assessment of Hand Cleaning Treatments on the Survival and Transmission of L. fungicola
2.4. In Vitro Assessment of Antifungal Activity of Hand Cleaning Products against L. fungicola
2.5. Effect of Two ABHS Gels on the Survival of L. fungicola Conidia on the Hands of Multiple Subjects
3. Results
4. Discussion
5. Conclusions
Author Contributions
Funding
Institutional Review Board Statement
Informed Consent Statement
Data Availability Statement
Acknowledgments
Conflicts of Interest
References
- Fletcher, J.T.; Gaze, R.H. Mushroom Pests and Disease Control; Manson: London, UK, 2008; pp. 70–75. [Google Scholar]
- Wong, W.C.; Preece, T.F. Sources of Verticillium fungicola on a commercial mushroom farm in England. Plant Pathol. 1987, 36, 577–582. [Google Scholar] [CrossRef]
- Berendsen, R.L.; Baars, J.J.P.; Kalkhove, S.I.C.; Lugones, L.G.; Wosten, H.A.B.; Bakker, A.H.M. Lecanicillum fungicola: Causal agent of dry bubble disease in white-button mushroom. Mol. Plant Pathol. 2010, 11, 585–595. [Google Scholar]
- Shamshad, S.A.; Clift, A.D.; Mansfield, S. The effect of tibia morphology on vector competency of mushroom sciarid flies. J. Appl. Entomol. 2009, 133, 484–490. [Google Scholar] [CrossRef]
- Grogan, H.; Gaze, R.H. Identification and Control of Dry Bubble Disease of Mushrooms; HDC Factsheet 09/08; Horticultural Development Company, East Malling: Kent, UK, 2008; Available online: http://hdl.handle.net/11019/1802 (accessed on 9 August 2021).
- Pyck, N.; Grogan, H. MushTV Factsheet 04/15. Fungal Diseases of Mushrooms and Their Control. 2015. Available online: https://www.teagasc.ie/publications/2015/fungal-diseases-of-mushrooms-and-their-control.php (accessed on 9 August 2021).
- Piasecka, J.; Kavanagh, K.; Grogan, H. Detecting Bubble Trouble in Mushrooms. TResearch: Autumn 2012. 8 October 2012, pp. 26–27. Available online: https://www.teagasc.ie/publications/2012/tresearch-autumn-2012.php (accessed on 9 August 2021). summarised from Piasecka, J.; Kavanagh, K.; Grogan, H. Detection of sources of Lecanicillium (Verticillium) fungicola on mushroom farms. In Mushroom Biology and Mushroom Products; Savoie, J.M., Foulonge-Oriol, M., Largeteau, M., Barroso, G., Eds.; INRA: Arcachon, France, 2011; pp. 484–489.
- Boyce, J.M.; Pittet, D. Guideline for hand hygiene in health care settings: Recommendations of the Healthcare Infection Control Practices Advisory Committee and the HICPAC/SHEA/APIC/IDSA Hand Hygiene Task Force. Infect. Control Hosp. Epidemiol. 2002, 23, S3–S40. [Google Scholar] [CrossRef]
- Grayson, M.L.; Melvani, S.; Druce, J.; Barr, I.G.; Ballard, S.A.; Johnson, P.D.R.; Mastorakos, T.; Birch, C. Efficacy of soap and water and alcohol based hand rub preparations against live H1N1 influenza virus on the hands of human volunteers. Clin. Infect. Dis. 2009, 48, 285–291. [Google Scholar] [CrossRef] [PubMed]
- Jabbar, U.; Leischner, J.; Kasper, D.; Gerber, R.; Sambol, S.P.; Parada, J.P.; Johnson, S.; Gerding, D.N. Effectiveness of alcohol based hand rubs for removal of Clostridium difficile spores from hands. Infect. Control Hosp. Epidemiol. 2010, 31, 565–570. [Google Scholar] [CrossRef]
- Singh, P.; Potlia, I.; Malhotra, S.; Dubey, H.; Chauhan, H. Hand Sanitizer an Alternative to Hand Washing—A Review of Literature. J. Adv. Oral Res. 2020, 11, 137–142. [Google Scholar] [CrossRef]
- Leslie, R.A.; Zhou, S.S.; Macinga, D.R. Inactivation of SARS-CoV-2 by commercially available alcohol-based hand sanitizers. Am. J. Infect. Control 2021, 49, 401–402. [Google Scholar] [CrossRef] [PubMed]
- Fendler, E.; Groziak, P. Efficacy of alcohol based sanitizers against fungi and viruses. Infect. Control Hosp. Epidemiol. 2002, 23, 61–62. [Google Scholar] [CrossRef] [PubMed]
- World Health Organisation. Consensus recommendations. In WHO Guidelines on Hand Hygiene in Health Care; WHO Press: Geneva, Switzerland, 2009; pp. 151–156. [Google Scholar]
- World Health Organisation. Surgical hand preparation: State of the art. In WHO Guidelines on Hand Hygiene in Health Care; WHO Press: Geneva, Switzerland, 2009; pp. 54–60. [Google Scholar]
- Marchetti, M.G.; Kampf, G.; Finzi, G.; Salvatorelli, G. Evaluation of the bactericidal effect of five products for surgical hand disinfection according to prEN 12054 and prEN 12791. J. Hosp. Infect. 2003, 54, 63–67. [Google Scholar] [CrossRef]
- World Health Organisation. Methods to evaluate the antimicrobial efficacy of handrub and hand wash agents and formulations for surgical hand preparation. In WHO Guidelines on Hand Hygiene in Health Care; WHO Press: Geneva, Switzerland, 2009; pp. 25–29. [Google Scholar]
- Ogle, H.; Brown, J. Vector-borne inoculum. In Plant Pathogens and Plant Disease; Brown, J.F., Ogle, H.J., Eds.; Rockvale Publications: Berringer, NSW, Australia, 1997; pp. 231–241. [Google Scholar]

| Test Product | Product Composition |
|---|---|
| Liquid soap 1 (Ultimatic N99930, Georgia-Pacific, Nokia, Finland (Discontinued, similar alternatives at https://www.gppro.com/ accessed on 3 August 2021) | Aqua, Sodium Laureth Sulfate, PEG-4-Rapeseedamide, Cocamidopropyl Betaine, MEA-Lauryl Sulphate, Sodium Chloride, Propylene Glycol, Glycerine, 2-Phenoxyethanol, Sodium Benzoate, Glycol Stearate, Parfum, Dehydroacetic Acid, Cocamide MEA, Cocamide DEA, Octoxyglycerin, Citric Acid. |
| Liquid soap 2 1 (Carex Bacteria Protect with Zinc, Cussons, Manchester, UK https://carex.co.uk/ accessed on 3 August 2021) | Aqua, Sodium Laureth Sulfate, Cocamidopropyl Betaine, Lactic Acid, Sodium Chloride, Glycerin, Polyquaternium-7, Parfum, Zinc Coceth Sulfate, Sodium Benzoate, Styrene/Acrylates Copolymer, Tetrasodium Glutamate Diacetate, Benzotriazol Dodecyl p-Cresol, Polysorbate 20, Citronellol, Coumarin, Hexyl Cinnamal, Butylphenyl Methypropional, CI 42090. |
| Alcohol-based hand sanitiser gel 1 (SteriClean, Advanced Technology Products, Limerick, Ireland, https://www.atp.ie/ accessed on 3 August 2021) | 60–70% ethanol, 1–10% glycerine, 0–0.5% cyclohexane, 0–0.5% acrylic acid copolymer, 0–0.5% ethylacetate. |
| Alcohol-based hand sanitiser gel 2 1 (HypaClean, Safety First Aid Group, London, UK, https://www.safetyfirstaid.co.uk// accessed on 3 August 2021) | 70% denaturated ethanol, Aqua, Glycerin, Lauryl, Aminopropylglycine, Chlorhexidine Digluconate. |
| Test Product | L. fungicola CFUs/mL | % Viability after Treatment (Log10 Reduction) | ||
|---|---|---|---|---|
| L. fungicola conidial suspension | Test Product solution (1:10) Time zero | Test Product solution (1:10) Time 1 min | ||
| Tap Water Control | 1.4 × 106 | 1.4 × 105 (Log10 = 5.146) | 1.4 × 105 (Log10 = 5.146) | 100% (0) |
| Soap 1 | 1.4 × 106 | 1.4 × 105 (Log10 = 5.146) | 1.3 × 105 (Log10 = 5.114) | 93% (<1 Log10) |
| Soap 2 | 1.4 × 106 | 1.4 × 105 (Log10 = 5.146) | 1.0 × 105 (Log10 = 5) | 71% (<1 Log10) |
| ABHS gel 1 | 1.4 × 106 | 1.4 × 105 (Log10 = 5.146) | ≤1.0 × 101 (Log10 = 1) | <0.01% (>4 Log10) |
| ABHS gel 2 | 1.4 × 106 | 1.4 × 105 (Log10 = 5.146) | ≤1.0 × 101 (Log10 = 1) | <0.01% (>4 Log10) |
| Subject | Hand Size (cm2 approx) | Hand Temp. °C | Number of Fingertip Imprints out of 100 with L. fungicola | |||
|---|---|---|---|---|---|---|
| ABHS gel 1 | ABHS gel 2 | |||||
| 1.5 mL | 3.0 mL | 1.5 mL | 3.0 mL | |||
| 1 (female) | - 1 | - | 0 | 0 | 3 | 0 |
| 2 (female) | 152 | 27 | 0 | 0 | 0 | 0 |
| 3 (male) | 203 | 32 | 1 | 0 | 1 | 0 |
| 4 (female) | 143 | 21 | 0 | 0 | 1 | 0 |
| 5 (male) | 211 | 32 | 10 | 0 | 81 | 0 |
Publisher’s Note: MDPI stays neutral with regard to jurisdictional claims in published maps and institutional affiliations. |
© 2021 by the authors. Licensee MDPI, Basel, Switzerland. This article is an open access article distributed under the terms and conditions of the Creative Commons Attribution (CC BY) license (https://creativecommons.org/licenses/by/4.0/).
Share and Cite
McGuinness, B.; Baqué, E.; Grogan, H. Efficacy of Liquid Soap and Alcohol-Based Hand Sanitisers in Eradicating Viable Conidia of the Mushroom Pathogen Lecanicillium fungicola on Contaminated Hands. Agronomy 2021, 11, 1600. https://doi.org/10.3390/agronomy11081600
McGuinness B, Baqué E, Grogan H. Efficacy of Liquid Soap and Alcohol-Based Hand Sanitisers in Eradicating Viable Conidia of the Mushroom Pathogen Lecanicillium fungicola on Contaminated Hands. Agronomy. 2021; 11(8):1600. https://doi.org/10.3390/agronomy11081600
Chicago/Turabian StyleMcGuinness, Brian, Elodie Baqué, and Helen Grogan. 2021. "Efficacy of Liquid Soap and Alcohol-Based Hand Sanitisers in Eradicating Viable Conidia of the Mushroom Pathogen Lecanicillium fungicola on Contaminated Hands" Agronomy 11, no. 8: 1600. https://doi.org/10.3390/agronomy11081600
APA StyleMcGuinness, B., Baqué, E., & Grogan, H. (2021). Efficacy of Liquid Soap and Alcohol-Based Hand Sanitisers in Eradicating Viable Conidia of the Mushroom Pathogen Lecanicillium fungicola on Contaminated Hands. Agronomy, 11(8), 1600. https://doi.org/10.3390/agronomy11081600
